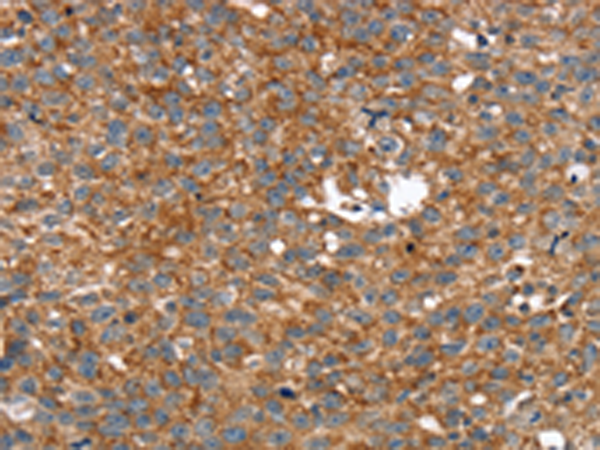
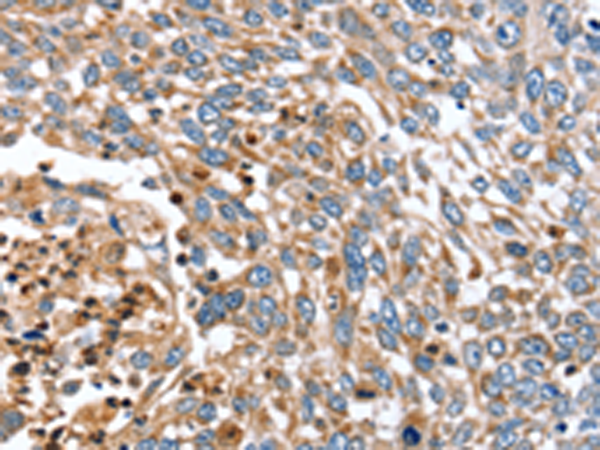
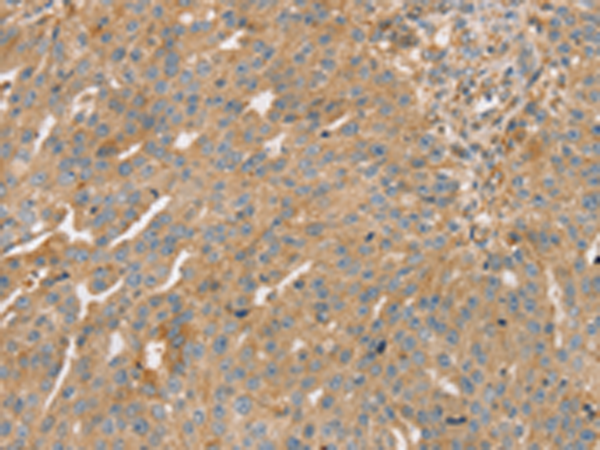

-
分类: 科研抗体货号: P08795别名: ATG24B应用: IHC反应种属: Human, Mouse
-
分类: 科研抗体货号: P08824别名: SVH; PNAS112; PNAS-112; PSEC0198应用: IHC反应种属: Human
-
分类: 科研抗体货号: P08813别名: NZF3; ZNF387; ZC2HC10应用: IHC反应种属: Human, Mouse, Rat
-
分类: 科研抗体货号: P08823别名: PSAP; PSPA; SP-A; SPA2; PSP-A; SFTP1; SP-2A; SPAII; COLEC5; SFTPA2B应用: IHC反应种属: Human
-
分类: 科研抗体货号: P08829别名: SYN16应用: WB,IHC反应种属: Human, Mouse
-
分类: 科研抗体货号: P08810别名: SSRC; CT5.1应用: WB反应种属: Human
-
分类: 科研抗体货号: P08822别名: RRP14应用: WB,IHC反应种属: Human
-
分类: 科研抗体货号: P08828别名: STX13; STX14应用: WB反应种属: Human, Mouse, Rat
-
分类: 科研抗体货号: P08840别名: C22orf4; HSC79E021应用: WB,IHC反应种属: Human, Mouse
-
分类: 科研抗体货号: P08820别名: HST; ST2; STD; hSTa; DHEAS; ST2A1; ST2A3; DHEA-ST应用: WB,IHC反应种属: Human

鄂公网安备42018502007531号
鄂公网安备42018502007531号

